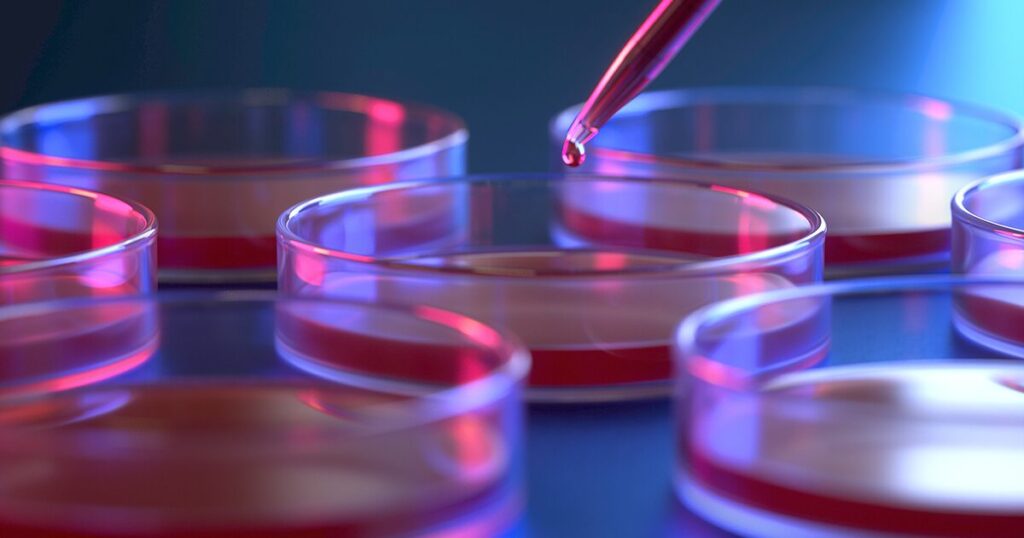

O jejum intermitente, prática que alterna períodos de alimentação com períodos de abstinência, ganhou popularidade nos últimos anos como ferramenta de emagrecimento e melhora da saúde. No entanto, novas pesquisas mostram que seus benefícios podem ir além da balança, atingindo diretamente o fígado — órgão vital para o metabolismo de gorduras, proteínas e carboidratos.
Gordura no fígado: um problema crescente
- A esteatose hepática não alcoólica (gordura no fígado) afeta milhões de pessoas no mundo, sendo considerada uma das doenças mais comuns relacionadas ao estilo de vida moderno.
- O acúmulo de gordura pode evoluir para inflamações, fibrose e até cirrose, aumentando o risco de câncer hepático.
Evidências Científicas
Pesquisas internacionais
- Instituto Alemão de Pesquisa do Câncer (DKFZ): estudos mostraram que o jejum intermitente protege contra inflamações hepáticas e reduz o risco de câncer no fígado. Além disso, alguns medicamentos parecem mimetizar parcialmente os efeitos do jejum, abrindo caminho para novas terapias.
- Universidade de Sydney (Austrália): pesquisadores identificaram que o jejum altera proteínas fundamentais no fígado, como a HNF4-alfa, responsável por regular centenas de genes. Essa modificação ajuda a reduzir inflamações e melhora o metabolismo dos ácidos graxos.
- Estudos clínicos em humanos: resultados indicam que períodos controlados de jejum podem melhorar a tolerância à glicose, reduzir resistência à insulina e diminuir marcadores de inflamação.
Pesquisas brasileiras
- Especialistas destacam que o jejum intermitente pode ser uma alternativa para pacientes com gordura no fígado, desde que acompanhado por profissionais de saúde. No Brasil, médicos alertam que a prática não deve ser vista como solução milagrosa, mas sim como parte de um estilo de vida saudável.
Benefícios Identificados
- Redução da gordura hepática: melhora significativa em pacientes com esteatose.
- Controle da glicemia: maior sensibilidade à insulina.
- Diminuição da inflamação: redução de proteínas ligadas a processos inflamatórios.
- Prevenção de doenças: menor risco de evolução para cirrose e câncer hepático.
- Impacto positivo em doenças crônicas: potencial benefício para diabetes tipo 2 e doenças cardiovasculares.
Limitações e Cuidados
Apesar dos resultados animadores, especialistas reforçam que:
- O jejum intermitente não é indicado para todos. Pessoas com problemas de saúde específicos, gestantes, idosos e crianças devem evitar ou adaptar a prática.
- É fundamental acompanhamento médico e nutricional, para garantir que o jejum não cause deficiências nutricionais ou efeitos colaterais.
- O tipo de jejum (16h, 24h, dias alternados) deve ser escolhido de acordo com o perfil do paciente.
Perspectivas Futuras
Pesquisadores acreditam que o jejum intermitente pode se tornar uma ferramenta terapêutica complementar no tratamento da gordura no fígado e de doenças metabólicas. Além disso, há estudos em andamento para desenvolver medicamentos que imitem os efeitos do jejum, oferecendo alternativas para quem não consegue aderir à prática.
Conclusão
O jejum intermitente surge como uma estratégia promissora para melhorar a saúde do fígado e reduzir riscos de doenças graves. No entanto, não deve ser encarado como solução única ou imediata. A combinação de alimentação equilibrada, acompanhamento médico e estilo de vida saudável continua sendo o caminho mais seguro para proteger o fígado e garantir qualidade de vida.

+ There are no comments
Add yours